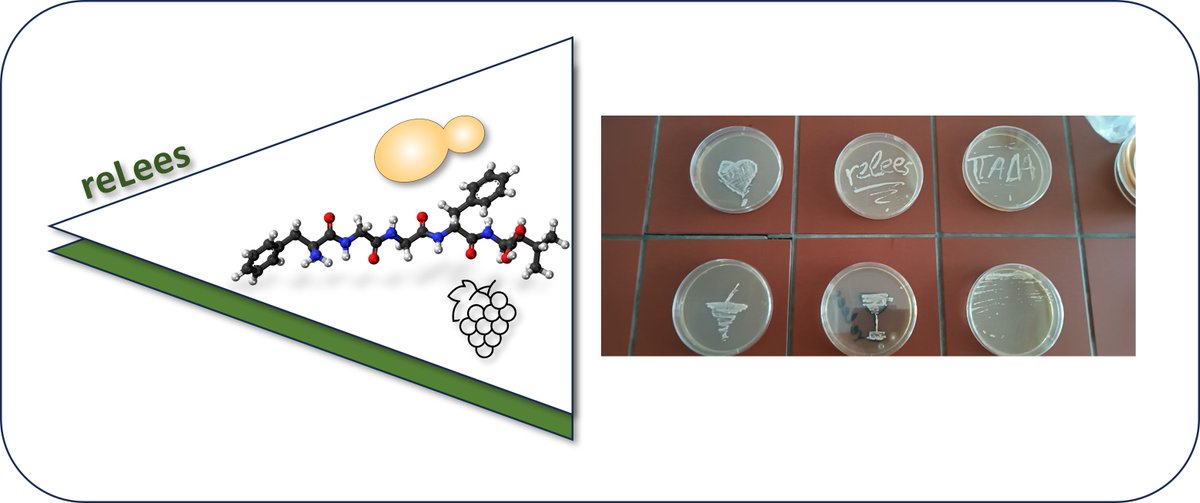
polyphenologist tweet media

Sabitlenmiş Tweet

265 GB of data and rich #metadata can be found on a @MetaboLights #FAIR study about #wine shelf life: ebi.ac.uk/metabolights/M…
#metabolomics #lightstrike #terpens #norisoprenoids #bigdata #GCxGC
doi.org/10.1073/pnas.2…

English
polyphenologist
987 posts

@polyphenologist
Metabolomics; Food Chemistry; Wine Science. Life project: Save the world from bad wine. Affiliations: @uniwa_gr @fondazionemach @grppolyphenols IVAS